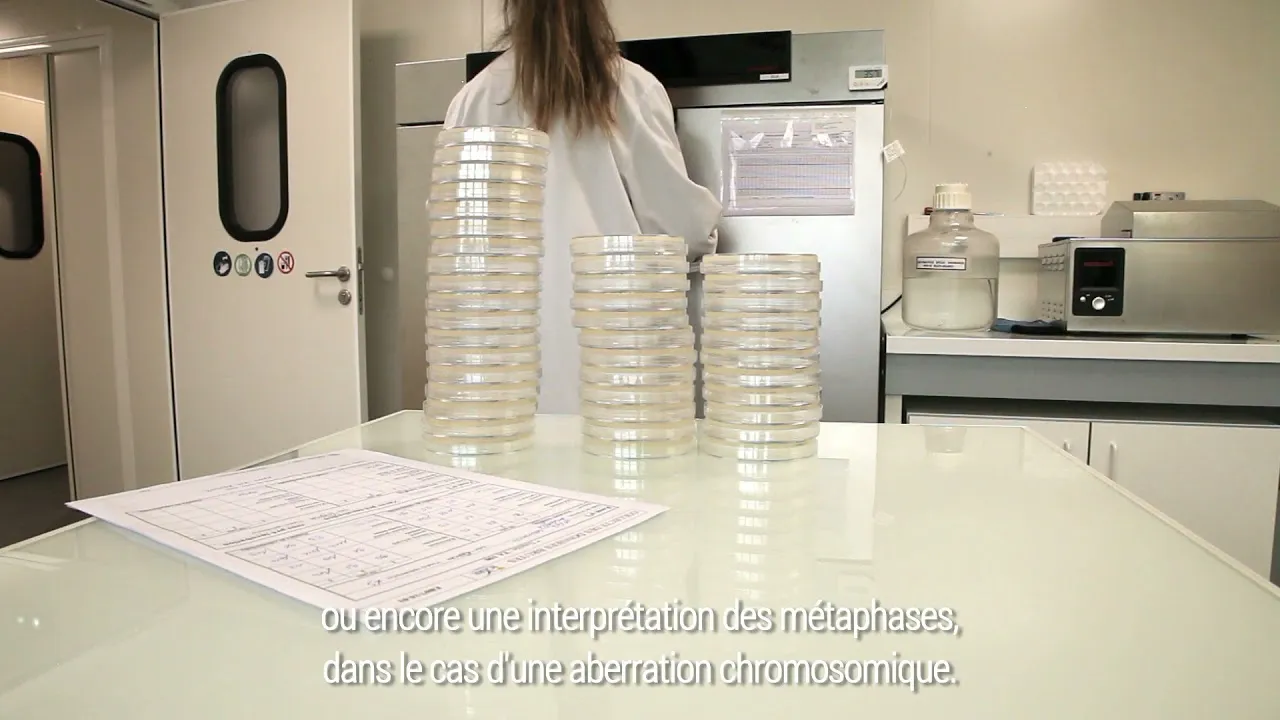

Emplois & carrière
Offres d’emploi
Dans le cadre de notre développement, nous sommes à la recherche de nouveaux talents prêts à contribuer à notre croissance et relever de nouveaux défis !
Notre expertise et notre pluridisciplinarité dans la sécurité des produits de santé nous permettent de proposer des parcours motivants sur nos différents domaines de compétences et d’accompagner chaque collaborateur dans son développement professionnel.
Si vous souhaitez intégrer une entreprise dynamique et leader sur son secteur, rejoindre une équipe à taille humaine et partageant des valeurs fortes, que vous soyez débutants ou expérimentés, nos opportunités peuvent vous intéresser !
Nous recrutons des collaborateurs pour nos sites situés à Saint-Beauzire (63360) et Martillac (33650).
Rejoindre Icare
Le groupe Icare propose depuis plus de 25 ans, des prestations permettant à ses clients d’avoir l’assurance que le dispositif ou le produit fabriqué mis sur le marché est conforme aux exigences règlementaires ou normatives.
Du concept, au contrôle de la production, le Groupe Icare guide chaque client à chaque étape de la vie des produits de santé.
Présent à Clermont-Ferrand, Bordeaux, en Suisse et au Brésil, le Groupe Icare emploie plus de 220 collaborateurs.
Rejoindre Icare, c’est travailler au sein d’un Groupe International, dans une dynamique de croissance et Expert dans la Sécurité des Produits de Santé. Nous sommes une équipe à taille humaine partageant des valeurs de collaboration, solidarité et excellence opérationnelle au service du client.

Nos chiffres clé
Chiffres clés : une équipe de plus de 220 collaborateurs dans le monde dont 30 masters II & ingénieurs et 12 PhD.
69% de femmes, 31% d’hommes
Des effectifs